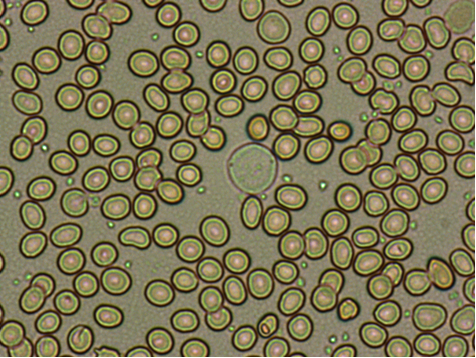

血小板神操作的真真假假,你学会了吗?
真实的血小板聚集
在此,举一个典型的EDTA依赖性血小板减少案例说明,如图1、2分别是干片和湿片的镜检,红色框框为血小板聚集现象,红色箭头为单个独立的血小板。
(说明:干片为推片后,血片干燥后的镜检;湿片为一滴血液加一滴生理盐水均匀涂片镜检。)

图1,干片镜检

图2,湿片镜检
但在实际工作中,却总会遇到一些特殊或者说奇怪的现象,血球仪报警信息血小板聚集(PLT Clumps?),但镜检却始终未见血小板聚集,到底是什么因素在干扰?另外,发现一些同事在运用神操作时,容易将一些杂质或其它物质认为是血小板或血小板聚集,从而无法准确判断出血小板到底聚集了没有。
虚假的血小板聚集
如图3、4,红色箭头为真实的血小板,黑色箭头为杂质,该杂质成絮状拉丝一样,经验不足的老师很容易将其误认为是血小板聚集。

图3,真血小板和杂质

图4,真实血小板和杂质
该如何识别这些杂质和真实的血小板呢?如图5、6,只需要高倍镜下细调焦螺旋,真实的血小板细调焦后会有折光性(成小亮点),而杂质通常没有。

图5
图6
另外,需要注意的是,嗜酸性粒细胞和嗜碱性粒细胞破碎后散落出来的颗粒,在干湿片不染色的情况下,极其容易与血小板相混淆,尤其是破碎后散落出来的一堆颗粒,极其误认为是血小板聚集。它们之间的鉴别,只需要把握两点:嗜酸/嗜碱性粒细胞颗粒的大小比真实的血小板还要小很多(如图7、8所示);嗜酸/嗜碱性粒细胞即便破碎了,在不染色情况下镜检,我们仍可以看到颗粒附近有核的存在,且散落的颗粒包围着核,而通常来说真实的血小板聚集一般不会围绕在白细胞一圈或半圈。

图7,血小板和破碎的嗜酸性粒细胞

图8
接下来,我们就来看看遇到比较多的仪器和镜检不符情况。以实际案例说明,进行逐步解析,如图9,为12月18日13号标本,PLT 105×109/L,血球仪提示血小板聚集(PLT Clumps?)。

图9
仪器Q--Flags显示PLT Clumps?达到260范围,已超出仪器自身设定的100阈值,如图10。

图10
如果是按照普通的复检规则,我们肯定是要进行推片染色镜检,可发现镜下却没有聚集。到底怎么回事呢?不急,答案却在干片里,如图11,红色箭头为真实的血小板,蓝色箭头为白细胞,黑色箭头为一种丝状物质。

图11
是不是不够清晰,再来一张图片,如图12,这丝状物质还真是卷曲、扭曲。

图12
看到这,有些老师会疑惑了,既然干片能镜检发现这些丝状物质,那为什么染色后却看不见?答案是:确实会看不见,特别是在滴加香柏油后,消失的更是明显。个人经验,有些标本染色后,其背景依稀能隐约看到一些丝状物质,在滴加香柏油后,立即消失不见。
当然了,可能还有老师会问:这些丝状物质,难道就不是推片的刮痕?或者是玻片自身不干净?这些情况,自己都进行了排除,使用的是干净玻片,推片的刮痕并不是此番模样。
疑问涌现
这些丝状物质到底是什么呢?仪器为什么会认为它们是血小板聚集呢?
首先,丝状物质可能是消毒时擦拭皮肤处的棉签,残留有非常微小的棉丝,肉眼难以辨认,经采血针进入采血管。但也不排除皮肤处的某些杂质、采血困难且耗时长时已经激发凝血功能产生的细小凝丝(纤维蛋白丝?)。
其次,仪器会认为该丝状物质为血小板聚集,是由仪器测试原理所决定。血球仪在计数血小板时,特别是阻抗法计数的血小板,当丝状物质通过计数孔时,一连串的脉冲信号,加上体积又小,达到设定的阈值后,仪器自然会报警血小板聚集。
可以抽象的想象下,干片环境下,我们看到的血细胞和丝状物质,就相当于仪器吸取血液后进行计数和分类的模式一样。只不过白细胞分类时,仪器有染色液进行染色从而进行DIFF分类,但血小板计数如果只有阻抗法的仪器,这丝状物质不就当成了血小板聚集。
除了图11、12明显的丝状物质外,也有如图13这种不明显的丝状物质,长长的细丝状物质。

图13
总结
在运用血小板聚集的神操作时,一定要多加浏览和观察,熟能生巧,甄别出真假血小板聚集。神操作的推出只是为了方便快捷鉴别,对于一人当班又事情繁忙时,非常实用。当然,最可靠的方法还是要进行染色镜检,不可偷懒。

